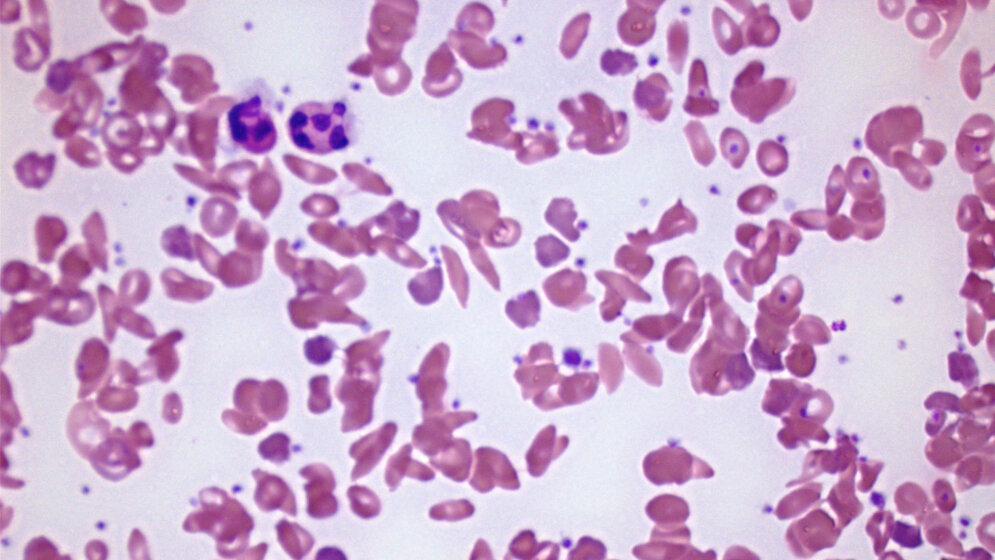
Blutausstrich_bei_Sichelzellanaemie_Rick_Jan_Kluitenberg_eigenes_Werk_CC_BY_SA_3_0.jpg Blutausstrich bei Sichelzellenanämie

Die klinische Prüfung wurde von Prof. Marina Cavazzana in Zusammenarbeit mit Prof. Philippe Leboulch (CEA/Paris-Süd Medizinische Fakultät/Harvard Medizinische Fakultät) [1] geleitet. Die Ergebnisse wurden am 2. März 2017 in der Fachzeitung „New England Journal of Medicine“ veröffentlicht. Das französische Forscherteam in Paris (Hôpital Necker Enfants malades, AP-HP, Institut Imagine) hatte im Oktober 2014 eine Gentherapie an einem 13-jährigen Patienten mit Sichelzellenanämie durchgeführt.
Die Sichelzellenanämie ist die weltweit häufigste genetische Erkrankung: etwa 50 Millionen Menschen tragen die Mutation in sich oder sind bereits erkrankt. Sie ist eine schwerwiegende Form der Anämie, die sehr starke Schmerzepisoden sowie Schädigungen an lebenswichtigen Organen, Infektionsempfindlichkeit, Eisenüberladung und endokrine Störungen verursacht.
Zur Behandlung des Patienten haben die Forscher zunächst hämatopoetische Stammzellen aus seinem Knochenmark entnommen, die für die Produktion von Blutzellen verantwortlich sind. Dann führten sie ein mit einem therapeutischen Gen ausgestatteten DNA-Vektor [2] in diese Zellen ein, um sie zu korrigieren. Im Anschluss wurden die behandelten Zellen dem Patienten injiziert.
Fünfzehn Monate nach der Transplantation brauchte der Patient keine Transfusion mehr. Er hatte keine Schmerzepisoden mehr und konnte in ein normales Leben zurückkehren. Die Forscher hoffen nun auf weitere klinische Tests, durch die viele Patienten geheilt werden können. (idw, red)
[1] CEA – Behörde für Atomenergie und alternative Energien
[2] Vektoren sind gentechnisch veränderte DNA-Elemente, die zur Übertragung und zum Einbau fremder DNA-Sequenzen in eine Wirtszelle verwendet werden.
Ribeil, J. A., Hacein-Bey-Abina, S., Payen, E., et al. (2017): Gene Therapy in a Patient with Sickle Cell Disease. New England Journal of Medicine, 376 (9), 848-855.
Artikel teilen